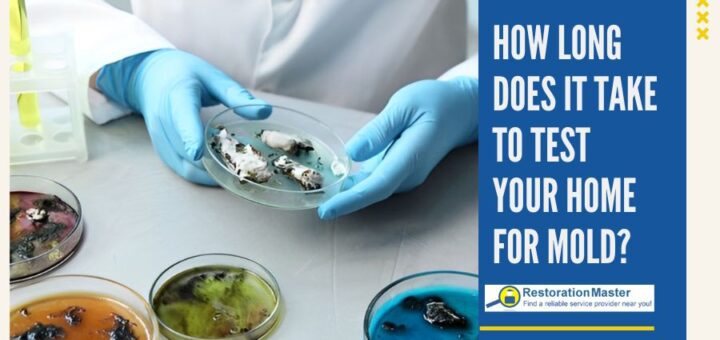
how long does it take to test your home for mold

Understanding the Accuracy of DIY Mold Testing Kits | Risks of False Negatives
Understanding the accuracy of home mold testing kits and the risk of false negatives in detecting toxic mold is essential. In this article, we’ll explore whether DIY mold kits are reliable and why they...